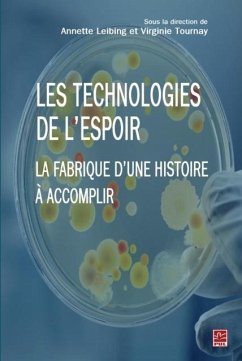

Suchergebnisse für "Presses de l'Universite Laval"
1856 Artikel gefunden
Zur ersten SeiteZur vorherigen Seite...Weitere Seiten 28 Zur Seite 28 29 Zur Seite 29 30 Zur Seite 30 31 Aktuelle Seite 32 Zur Seite 32 33 Zur Seite 33...Weitere Seiten38Zur letzten Seite, Seite 38Zur nächsten SeiteZur letzten Seite
Zur ersten SeiteZur vorherigen Seite...Weitere Seiten 30 Zur Seite 30 31 Aktuelle Seite...Weitere Seiten38Zur letzten Seite, Seite 38Zur nächsten SeiteZur letzten Seite
Ähnlichkeitssuche: Fact®Finder von OMIKRON